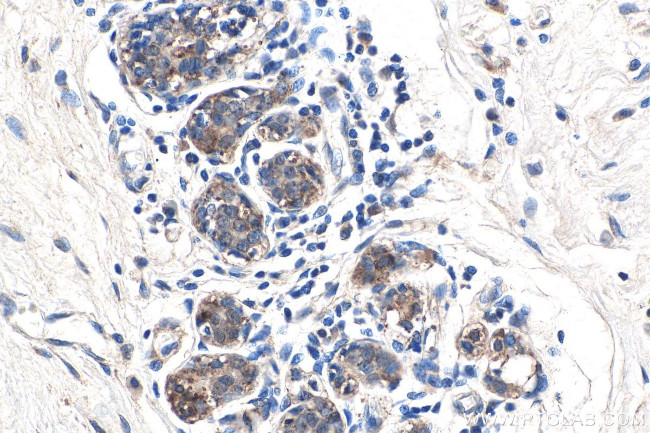
APPBP2 Antibody in Immunohistochemistry (Paraffin) (IHC (P))

Search
Proteintech
APPBP2 Polyclonal Antibody
{{$productOrderCtrl.translations['antibody.pdp.commerceCard.promotion.promotions']}}
{{$productOrderCtrl.translations['antibody.pdp.commerceCard.promotion.viewpromo']}}
{{$productOrderCtrl.translations['antibody.pdp.commerceCard.promotion.promocode']}}: {{promo.promoCode}} {{promo.promoTitle}} {{promo.promoDescription}}. {{$productOrderCtrl.translations['antibody.pdp.commerceCard.promotion.learnmore']}}
图: 1 / 10
APPBP2 Antibody (12409-1-AP150UL) in IHC (P)










产品信息
12409-1-AP150UL
种属反应
宿主/亚型
分类
类型
偶联物
形式
浓度
规格
纯化类型
保存液
内含物
保存条件
运输条件
靶标信息
The protein encoded by this gene interacts with microtubules and is functionally associated with beta-amyloid precursor protein transport and/or processing. The beta-amyloid precursor protein is a cell surface protein with signal-transducing properties, and it is thought to play a role in the pathogenesis of Alzheimer's disease. This gene has been found to be highly expressed in breast cancer. Multiple polyadenylation sites have been found for this gene.
仅用于科研。不用于诊断过程。未经明确授权不得转售。
篇参考文献 (0)
生物信息学
蛋白别名: amyloid beta precursor protein (cytoplasmic tail) binding protein 2; Amyloid beta precursor protein-binding protein 2; Amyloid protein-binding protein 2; APP-BP2; kinesin light chain-related protein; Protein interacting with APP tail 1; unnamed protein product
基因别名: APP-BP2; APPBP2; HS.84084; KIAA0228; PAT1
UniProt ID: (Human) Q92624
Entrez Gene ID: (Human) 10513